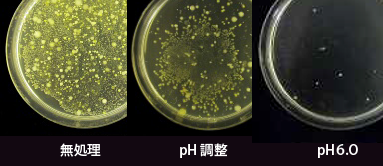
菌の増殖を抑えるスーパー次亜水

スーパー次亜水(弱酸性次亜塩素酸水溶液)は、食材や水道水、プールなど広範囲で使われている殺菌剤「次亜塩素酸ナトリウム」のpHを弱酸性に調整した除菌水です。
安全かつ強力な衛生管理用水として注目と信頼を受けています。
HSPでは、スーパー次亜水を活用した安全安心な環境整備のご提案とシステムのプランニングをおこなっています。
![]()

▶ 強い除菌力
○ スーパー次亜水は、従来より殺菌用に使われてきた次亜塩素酸ナトリウムの
pHを希塩酸で弱酸性に調整したものです。
弱酸性にすることにより除菌効果の高い次亜塩素酸の存在比が大きくなり、
除菌効果を高めることが可能です。
また、薬剤への抵抗性が高い芽胞菌やウイルスに対してもご使用いただけます。

○ pHの違いによる除菌効果の検証 (キュウリ試験/於・当社)試験方法)
市販のキュウリを同じ有効塩素濃度の次亜塩素酸ナトリウムと
スーパー次亜水(pH6.0)に30分間浸漬。
浸漬後、キュウリ表面をふき取り、一般生菌を測定しました。
殺菌が難しいといわれているキュウリですが、スーパー次亜水を使用することで 菌数の制御が可能です。
![]()
▶ 空間除菌消臭効果
○ スーパー次亜水空間除菌・消臭システムは、室内の空気を細かな
スーパー次亜水の霧で除菌・消臭します。
設備を導入することで、イヤなニオイのない快適な住空間に保ちます。
○ アンモニア、硫化水素、メルカプタン類など、
様々な悪臭物質に消臭効果を有しています。
芳香剤のように他のにおいでごまかすのではなく、
悪臭成分を元から分解するため、様々な場面での使用が可能です。
さらにスーパー次亜水を清掃と噴霧の両方で活用することによって、
より効果的に環境中の不快なにおいを消臭します。
特に、汚物臭・食物臭・ペット臭・タバコ臭などに高い効果があります。

▶ 高い安全性
○ スーパー次亜水は、低濃度で非常に高い除菌力をもっています。
弱酸性・低濃度で使用するため皮膚にやさしい除菌水です。
高い分解性と低い残留性をもち、環境にやさしい除菌水でもあります。
また食品や生体に直接使用しても影響がほとんどない安全性の高い資材です。
【安全性のテスト】
岡山大学との共同研究により、スーパー次亜水の安全性試験を行なっています。
各種試験を行い、いずれも安全性を確認しています。
▶ 経口投与試験:::ラットを用いたスーパー次亜水の経口投与試験
▶ 噴霧吸入試験:::ラットを用いたスーパー次亜水の噴霧試験
▶ 皮膚刺激性試験::ラットを用いたスーパー次亜水の皮膚刺激試験
▶ 眼刺激性試験:::ラットを用いたスーパー次亜水の眼刺激試験![]()
▶ 低コスト
○ 従来の殺菌消毒剤の価格と比較すると70%~80%の薬剤コスト軽減が可能です。
スーパー次亜水のランニングコストは、1Lあたり1円以下。薬剤コストを大幅に削減できます。
○ 作業時間の短縮により、人件費削減・作業の大幅な効率アップが実現します。
従来の次亜塩素酸ナトリウムよりも除菌力が高く、除菌スピードも速いため、
薬液量の低減、作業時間(20分⇒4分)短縮、使用水道水量低減(50~70%)のメリットがあります。![]()
▶ 環境負担が少ない
○ 従来から使用されてきた次亜塩素酸水はアルカリ性であり、排水する前に大量の中和剤を使用する必要がありました。
また高濃度で使用されていたため、環境に与える負荷も大きかったのです。
スーパー次亜水は環境に与える負荷が極めて少ないため、環境対策にもご活用いただいております。
それでは、環境負荷が少ないとはどういうことでしょうか?
【低残留性】
▶ 有機物接触で分解:排水中、自然環境中に存在する有機物に接触すると分解されます。
▶ 乾くと分解::::次亜塩素酸は水中でしか存在しないためスーパー次亜水は乾くと分解されます。
▶ 紫外線で分解:::次亜塩素酸は紫外線に長時間さらされると分解されます。
【低濃度で使用】
▶ スーパー次亜水は除菌効果が高いため低濃度で使用できます。
次亜塩素酸ナトリウムより低濃度(約5分の1)で使用できるため、環境負荷を減らすことができます。
【中和処理が不要】
▶ 高濃度で使用されてきた従来の次亜塩素酸ナトリウム水は、浄化槽のバクテリアに影響があったので、中和処理が必要でした。
スーパー次亜水は弱酸性・低濃度であり、また自然分解性が高いので、中和処理が不要です。
*大量にスーパー次亜水を使用される場合は、中和処理をお勧めしています。![]()
▶ Hsp2OのEPA認可内容
○ Hsp2Oの使用対象は、非多孔性の無生物硬表面となります。
使用場所は、病院、歯科診療所、家庭、公共施設、保育施設、ヘルスクラブ、実験・研究室、獣医やペット施設を含む商業施設、
食品加工施設、農業施設、輸送、ホスピタリティー施設、工業施設等での使用が可能です。
▶ EPAとは?
アメリカ合衆国環境保護庁 (Environmental Protection Agency)の略称。市民の健康保護と自然環境の保護を目的とするアメリカ合衆国連邦政府の行政機関です。EPAは環境表面を対象とする消毒剤について、効果と安全基準を確認し、認可を行います。
米国の医療機関ではCDC(Centers For Disease Control and Prevention/米国疾病予防センター)のガイドラインが院内感染対策の基準となっており、EPAやFDA(Food and Drug Administration/米国食品医薬品局)の認定登録品を使用するよう推奨されています。







